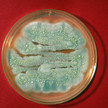
Penicillin in der Petrischale.

Thema: Engpass
Artikel zum Thema
Förderprogramm für EU-Produktion Engpässe: Holetschek warnt vor China
Aus Sorge vor zu großen Abhängigkeiten von anderen Ländern fordert Bayerns Gesundheitsminister Klaus Holetschek vom Bund ein Förderkonzept für mehr... Mehr»
Lieferengpass ACC ab Menge 30: Hexal verschickt Angebot – aus Versehen
Peinliche Panne bei Hexal: Der Generikakonzern hat an Apotheken ein Überweisungsangebot für ACC verschickt. Der Hustenlöser ist aber derzeit nicht lieferbar. So... Mehr»
Fiebersaft bis Ende November bestellbar Phoenix: Nurofen als Sonderkontingent
Fiebersäfte für Kinder sind weiterhin Mangelware, die Nachfrage nach Nurofen & Co. ist riesig. So überrascht eine Meldung des Großhändlers Phoenix, der ein... Mehr»
Ärztepräsident fordert „New Deal“ Reinhardt: Verwendungsrecht für neue Antibiotika
Der Präsident der Bundesärztekammer (BÄK), Dr. Klaus Reinhardt, fordert einen „New Deal für die Entwicklung neuartiger Antibiotika“. Mehrere große... Mehr»
Infanrix, Priorix, Varilix Impfstoffe für Grundimmunisierung werden knapp
Für wichtige Impfstoffe zur Grundimmunisierung von Kindern melden Hersteller aktuell Lieferengpässe. Apothekenteams müssen daher nun auch bei Vakzinen zur drei-... Mehr»
Apotheker schreibt an Ärzte Fiebersäfte: Wohlhabende Eltern kaufen Rezepturen
Fiebersäfte für Kinder sind weiter Mangelware. Rezepturen können die Lücken mancherorts stopfen, sofern die Apothekenteams mit der Herstellung hinterherkommen... Mehr»
Engpass bei Diabetesmedikament Ozempic: Hype als „Abnehmspritze“
Die Deutsche Gesellschaft für Endokrinologie (DGE) warnt vor dem Off-label-Use von Semaglutid. Um den Wirkstoff, bekannt unter dem Handelsnamen Ozempic, gibt es... Mehr»
Weitere Lieferengpässe für Antibiotika Penicillin wird knapp
Eines der wichtigsten Antibiotika ist aktuell knapp: Penicillin. Der Trockensaft zum Anfertigen einer gebrauchsfertigen Suspension und Tabletten in... Mehr»
Alternativen müssen ärztlich abgeklärt werden Insulin: Lieferengpass für Novorapid Flexpen
Novo Nordisk meldet neben dem Lieferengpass für Novorapid Flexpen 5 x 3 ml aktuell einen weiteren für den 10 x 3 ml NovoRapid Fertigpen. Für Diabetiker:innen... Mehr»
Lieferengpass bei Immunglobulin Cutaquig: Produktion wird wieder hochgefahren
Der Lieferstopp von Cutaquig ist beendet, die Produktion des lebenswichtigen Immunglobulins läuft wieder an. Hersteller Octapharma weist jedoch auf... Mehr»
Medien zum Thema
- 1